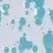

Productos al por mayor de Crow Canyon Home
Productos al por mayor de Crow Canyon Home
Productos al por mayor de Crow Canyon Home
Encuentra productos de miles de marcas para tu tienda.
Accede a precios mayoristasAcerca de Crow Canyon Home
Crow Canyon - Desde 1977, Crow Canyon Home ha estado creando utensilios de esmalte de alta calidad para aquellos que buscan el equilibrio perfecto entre una apariencia atemporal y una practicidad duradera. Los creadores del diseño clásico de salpicaduras, seguimos ofreciendo la mayor selección de colores de utensilios de esmalte, diversidad de productos e innovación al mundo. Somos una pequeña empresa certificada, propiedad de una mujer. ¡Ahora también vendemos utensilios de esmalte Golden Rabbit!